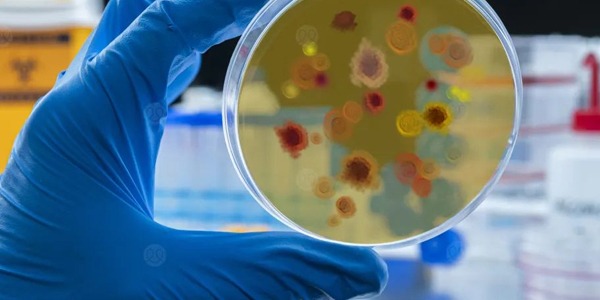

إعداد: تقوى البوسيفي
في إنجاز علمي واعد، كشف فريق دولي من الباحثين عن نوع من البكتيريا التي تعيش داخل الأورام، قادرة على إنتاج جزيء قوي يُعرف باسم “2-MiCit”، يتمتع بقدرة مزدوجة على مهاجمة الخلايا السرطانية وتعزيز فعالية العلاج الكيماوي بشكل كبير.
الدراسة التي نُشرت في مجلة Cell Systems قادها باحثون من مختبر العلوم الطبية (LMS) في لندن بالتعاون مع إمبريال كوليدج لندن وجامعة كولونيا الألمانية، وتشير نتائجها إلى أن هذا الاكتشاف قد يمثل نقطة تحول في فهم العلاقة بين الميكروبات والسرطان، ويمهد الطريق لتطوير جيل جديد من العلاجات الميكروبية المساندة للعلاج الكيماوي.
بكتيريا داخل الأورام
أظهرت الأبحاث الحديثة أن الأورام ليست مجرد تجمعات من الخلايا السرطانية، بل تستضيف أيضًا مجتمعات بكتيرية فريدة تؤثر في نموها واستجابتها للعلاج. ومع تطور تقنيات التحليل الجزيئي، بدأ العلماء بفهم الدور الحيوي الذي تؤديه هذه الميكروبات في بيئة الورم.
جزيء 2-MiCit.. هجوم مزدوج على السرطان
كشفت الدراسة أن جزيء 2-MiCit يعمل عبر آليتين متكاملتين:
1. استهداف الميتوكوندريا – مركز إنتاج الطاقة في الخلية – وتعطيل أحد الإنزيمات الأساسية فيها، مما يضعف قدرة الخلايا السرطانية على البقاء.
2. تلف الحمض النووي وتفعيل مسارات توقف النمو، ما يؤدي إلى إبطاء تطور الورم بشكل واضح.
كما تبين أن الجزيء يجعل الخلايا السرطانية أكثر حساسية للعلاج الكيماوي، إذ أظهر تعزيزًا كبيرًا لفعالية دواء “5-فلورويوراسيل” المستخدم على نطاق واسع، عند استخدامهما معًا.

نحو أدوية جديدة مستوحاة من الميكروبات
قال البروفيسور فيليبي كابريرو، قائد فريق البحث، إن هذا الاكتشاف يمثل “نقطة تحول في فهم الحوار الكيميائي بين البكتيريا والخلايا السرطانية”، موضحًا أن الجزيء المكتشف “يمكن أن يعمل كشريك قوي للعلاج الكيماوي، عبر تعطيل التمثيل الغذائي للخلايا السرطانية وزيادة هشاشتها أمام الدواء”.
وبالتعاون مع خبراء الكيمياء الطبية، نجح الفريق في تطوير نسخة اصطناعية محسّنة من الجزيء، أظهرت فعالية أعلى في قتل الخلايا السرطانية خلال التجارب المعملية.
من جانبه، قال الدكتور دانيال مارتينيز-مارتينيز، الباحث المشارك في الدراسة، إن “الميكروبات جزء أساسي من أجسامنا، وإن قدرة جزيء واحد على إحداث تأثير كبير في تطور السرطان تُعد مثالًا مذهلًا على تعقيد التفاعل بين الإنسان والميكروبات”.
أفاق مستقبلية
يفتح هذا الاكتشاف الباب أمام استراتيجيات علاجية مبتكرة، تستفيد من الميكروبات الطبيعية في تعزيز فعالية العلاجات التقليدية، وقد يقود مستقبلاً إلى تصميم أدوية ميكروبية هجينة أكثر دقة في استهداف الأورام وتقليل الأضرار الجانبية للعلاج الكيماوي.
 منصة الصباح الصباح، منصة إخبارية رقمية
منصة الصباح الصباح، منصة إخبارية رقمية